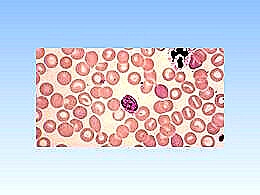
diaporama pps Nanorobots

Diaporama ‘Nanorobots’, de l'auteur Ginette.
Vous êtes actuellement sur la page du pps Nanorobots, un diaporama publié dans la catégorie Reportages.
Ginette, le créateur de ce pps fait parti des 200 contributeurs du site PPSMANIA. Retrouvez tous les diaporamas de Ginette dans sa catégorie:
Ginette, le créateur de ce pps fait parti des 200 contributeurs du site PPSMANIA. Retrouvez tous les diaporamas de Ginette dans sa catégorie:

joli, merci
très très intéressant ton pps un grand merci a++++++++++